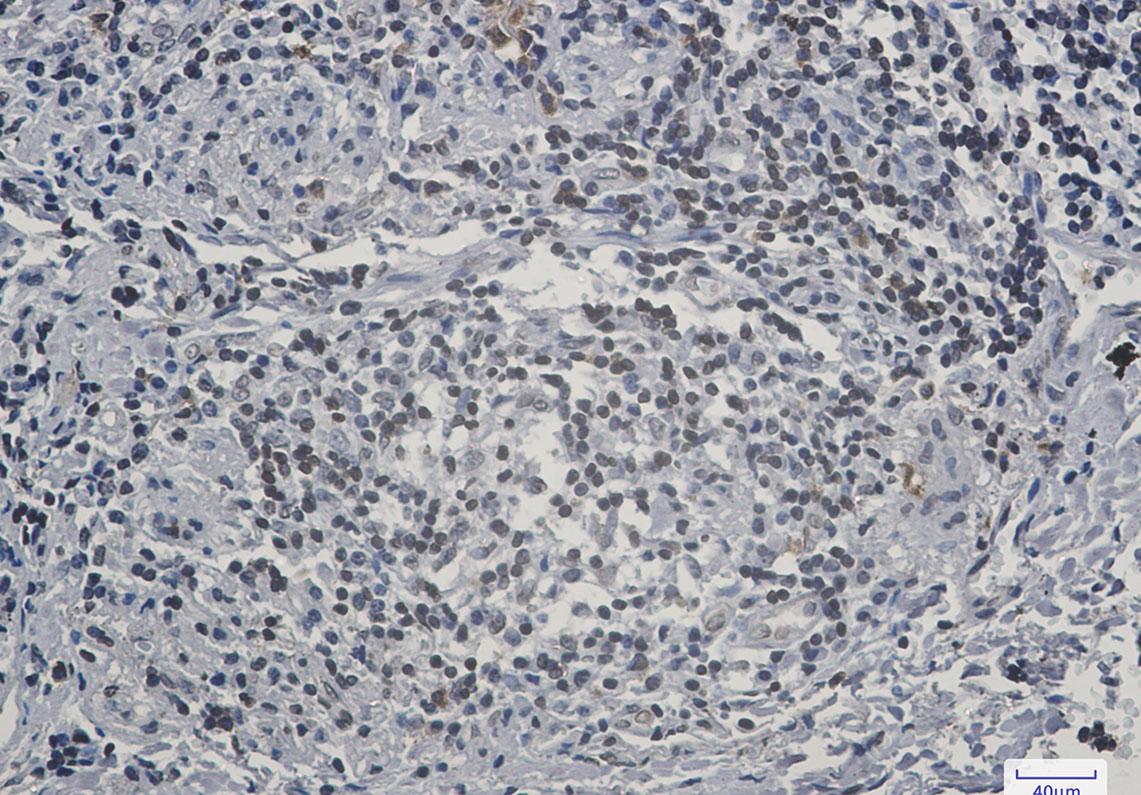

别名:PHA; LMN2R; TDRD18; DHCR14B; LBR应用:WB,IHC,IP
反应种属:Human
规格:50μl/100μl
| Description |
|---|
| The protein encoded by this gene belongs to the ERG4/ERG24 family. It localized in the nuclear envelope inner membrane and anchors the lamina and the heterochromatin to the membrane. It may mediate interaction between chromatin and lamin B. Mutations of this gene has been associated with autosomal recessive HEM/Greenberg skeletal dysplasia. Alternative splicing occurs at this locus and two transcript variants encoding the same protein have been identified. |
| Specification | |
|---|---|
| Aliases | PHA; LMN2R; TDRD18; DHCR14B; LBR |
| Entrez GeneID | 3930 |
| Swissprot | Q14739 |
| WB Predicted band size | Calculated MW: 71 kDa; Observed MW: 71 kDa |
| Host/Isotype | Rabbit IgG |
| Storage | Store at 4°C short term. Aliquot and store at -20°C long term. Avoid freeze/thaw cycles. |
| Species Reactivity | Human |
| Immunogen | A synthetic peptide of human Lamin B Receptor |
| Formulation | 50mM Tris-Glycine(pH 7.4), 0.15M NaCl, 40% Glycerol, 0.01% Sodium azide and 0.05% BSA |
| Application | |
|---|---|
| IP | 1/20 |
| WB | 1/500-1/1000 |
| IHC | 1/50-1/100 |
![]() |
Western blot analysis of Lamin B Receptor in K562, Hela lysates using Lamin B Receptor antibody. |
![]() |
Immunohistochemistry analysis of paraffin-embedded Human lung cancer using Lamin B Receptor antibody.High-pressure and temperature Sodium Citrate pH 6.0 was used for antigen retrieval. |
本公司的所有产品仅用于科学研究或者工业应用等非医疗目的,不可用于人类或动物的临床诊断或治疗,非药用,非食用。
暂无评论
本公司的所有产品仅用于科学研究或者工业应用等非医疗目的,不可用于人类或动物的临床诊断或治疗,非药用,非食用。
中文

发表回复